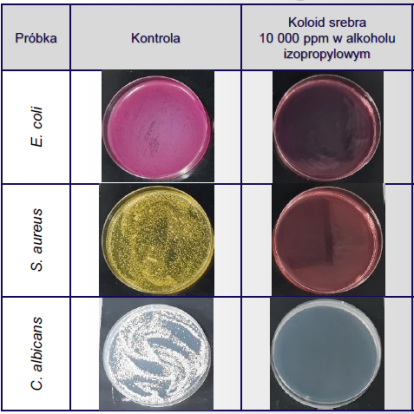

Alkoholowy koloid charakteryzuje się bardzo wysoką skutecznością działania, trwałością i zabezpieczaniem chronionej powierzchni przed rozwojem mikroorganizmów.
Nasz alkoholowy koloid srebra:
- w przeciwieństwie do obecnie stosowanych produktów wykazuje permanentne działanie,
- wykazuje skuteczność na poziomie powyżej 90%,
- jest środkiem o charakterystycznym zapachu bazującym na alkoholu izopropylowym,
- jest przyjazny środowisku poprzez zastąpienie preparatów opartych na biocydach
Preparat przetestowany pod kątem działania przeciw bakteriom oraz grzybom.
Oferowany w formie koncentratu o stężeniu 10 000 ppm srebra.
- Postać: klarowna ciecz o żółto pomarańczowym zabarwieniu
- Skład: alkohol izopropylowy, srebro koloidalne
- Zawartość srebra:10000 ppm (+/- 100 ppm)
- Termin przydatności: 6 miesięcy od daty produkcji(z zachowaniem właściwych warunków przechowywania).
- Aplikacja: Dokładnie wymieszać z docelowym produktem.
- Przechowywanie: Produkt pakowany w kanistry o pojemności 5 litrów .
Należy chronić przed słońcem oraz nie pozostawiać w silnym polu elektromagnetycznym .

Badania mikrobiologiczne
Wyniki badań TEM

Dlaczego koloid srebra?
Koloid charakteryzuje się bardzo wysoką skutecznością działania, trwałością i zabezpieczaniem chronionej powierzchni przed rozwojem mikroorganizmów Produkt oparty na cząstkach nanosrebra zapewnia długotrwałą skuteczność, zwiększenie bezpieczeństwa mikrobiologicznego i higieny, redukcję kosztów eksploatacyjnych zabezpieczonych materiałów wpływając na wymierne oszczędności.
Koloid srebra: Wybierz preparat bezpośrednio od producenta
Jako producent koloidów oferujemy nanokoloid srebra przeznaczony do stosowania jako dodatek do:
- środków dezynfekcyjnych i ochronnych
- formulacji opartych na środkach lotnych,
- żywic epoksydowych i akrylowych,
- poliuretanaów, farb i powłok
Producentów zainteresowanych wzbogaceniem swoich formuł o nanocząstki srebra zachęcamy do szczegółowego zapoznania się z naszym preparatem. W razie pytań lub wątpliwości pozostajemy do dyspozycji.
Zobacz również









































































